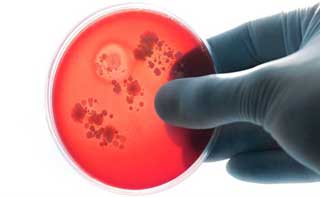

Описание состояния
Это заболевание известно под несколькими названиями. Ранее в патофизиологии использовался термин «тромбогеморрагический синдром». В современной медицине аббревиатура ДВС расшифровывается как «диссеминированное внутрисосудистое свертывание».
Среди синонимов можно встретить такие термины, как гиперкоагуляционный синдром и коагулопатия потребления.
ДВС-синдром представляет собой патологическое состояние, при котором в кровяной жидкости образуются тромбоцитарные и клеточные конгломераты, что в итоге приводит к закупорке сосудов микроциркуляторного русла.
Говоря простым языком, патогенез этого состояния характеризуется увеличением образования тромбов различных размеров.
Когда тромбы попадают в сосуды, они их блокируют, что вызывает нарушение свертываемости крови и приводит к обильным кровотечениям.
Такой процесс может наблюдаться при ряде заболеваний в области гинекологии и акушерства, включая:
- аборт;
- сепсис;
- инфекции бактериального происхождения;
- травмы.
В редких случаях заболевание может развиваться из-за ошибок, совершенных врачами во время хирургических вмешательств.
ДВС-синдром, или диссеминированное внутрисосудистое свертывание, представляет собой серьезное патологическое состояние, которое требует внимательного подхода со стороны медицинских специалистов. Врачи подчеркивают, что данное расстройство связано с активацией гемостаза, что приводит к образованию тромбов в мелких сосудах и, как следствие, к нарушению кровообращения. Это состояние может развиваться на фоне различных заболеваний, таких как сепсис, травмы или осложнения при беременности.
Медики отмечают, что своевременная диагностика и лечение ДВС-синдрома критически важны для предотвращения серьезных осложнений, включая органную недостаточность. Врачи рекомендуют внимательно следить за симптомами, такими как одышка, синюшность кожи и снижение артериального давления. Эффективное лечение включает в себя как устранение первопричины, так и применение антикоагулянтной терапии. Важно, чтобы пациенты находились под постоянным наблюдением, так как состояние может быстро прогрессировать.

Виды и фазы болезни
Классификация тромбогеморрагического синдрома основывается на клинических проявлениях и особенностях патогенеза.
С учетом механизма возникновения, заболевание можно разделить на следующие стадии:
- Гиперкоагуляция. На этом этапе в кровь поступает тромбопластин, который активно участвует в инициировании процессов свертывания и образования тромбов.
- Коагулопатия потребления. В этом периоде происходит активное использование свертывающих факторов, что со временем приводит к увеличению фибринолитической активности.
- Гипокоагуляция. В условиях интенсивного расхода компонентов свертывания развивается тромбоцитопения и несвертываемость.
- Фаза восстановления.
Таким образом, при воздействии повреждающего фактора (например, при кровотечениях или травмах) активируется защитная система – тромбоз. Однако на фоне бесконтрольного расхода свертывающих факторов возникает их дефицит, что приводит к гипокоагуляции.
При своевременной неотложной помощи возможно достижение восстановительной фазы.
В зависимости от клинических проявлений диссеминированное внутрисосудистое свертывание может проявляться в следующих формах:
- острая – длится до нескольких дней;
- подострая – возникает при хронических инфекционных процессах и аутоиммунных заболеваниях, продолжается несколько недель;
- хроническая – наблюдается при сердечно-сосудистых заболеваниях, поражениях почек и печени, а также на фоне сахарного диабета;
- рецидивирующая;
- латентная.
Кроме того, ДВС-синдром классифицируется на:
- локализованный – затрагивает один орган;
- локальный – может поражать несколько систем и органов, а также весь организм в целом.
Для выявления изменений в свертываемости крови проводят коагулограмму.
| Симптом | Описание | Возможные причины (в контексте ДВС-синдрома) |
|---|---|---|
| Кровотечения (кровоизлияния) | От легких кровотечений из носа до сильных внутренних кровотечений. | Дефицит тромбоцитов, потребление факторов свертывания крови, фибринолиз. |
| Тромбозы (образование тромбов) | Образование тромбов в кровеносных сосудах, приводящее к закупорке. | Активация системы свертывания крови, избыток тромбина. |
| Органная недостаточность | Снижение функции одного или нескольких органов (почки, печень, легкие). | Ишемия (недостаток кровоснабжения) из-за тромбозов, микротромбообразование в капиллярах. |
| Цианоз (синюшность кожи) | Синеватый оттенок кожи и слизистых оболочек. | Гипоксия (недостаток кислорода) из-за тромбозов в легочной артерии. |
| Дыхательная недостаточность | Затрудненное дыхание, одышка. | Тромбоэмболия легочной артерии (ТЭЛА). |
| Шоковое состояние | Резкое падение артериального давления, нарушение кровообращения. | Массивные кровотечения, обширное тромбообразование. |
Причины патологического процесса
ДВС-синдром редко выявляется как отдельное заболевание. Чаще всего ему предшествуют различные патологические состояния.
ДВС-синдром, или диссеминированное внутрисосудистое свертывание, вызывает множество обсуждений среди медицинских работников и пациентов. Многие отмечают, что это состояние может развиваться на фоне различных заболеваний, таких как сепсис, травмы или осложнения беременности. Люди часто делятся своими историями о том, как быстро развивались симптомы, и как важно своевременно обратиться за медицинской помощью. Врачи подчеркивают, что ранняя диагностика и лечение играют ключевую роль в спасении жизни. Некоторые пациенты, столкнувшиеся с этим синдромом, говорят о необходимости повышения осведомленности о его признаках, чтобы избежать серьезных последствий. Обсуждения в медицинских кругах акцентируют внимание на важности междисциплинарного подхода в лечении, что позволяет улучшить прогноз и качество жизни пациентов.

У взрослых
К числу основных факторов, способствующих развитию заболеваний у взрослых, относятся:
- септицемия;
- неблагоприятные последствия хирургического вмешательства;
- аутоиммунные заболевания;
- инфекционные и воспалительные процессы;
- злокачественные опухоли;
- резкое падение артериального давления;
- длительное применение медикаментов, которые могут нарушать свертываемость крови и повышать риск тромбообразования;
- отравление токсическими веществами.
Также нарушение может быть вызвано негативной реакцией организма на переливание крови.
У детей
ДВС-синдром широко встречается в акушерской практике, поскольку он часто наблюдается у новорожденных.
Основные причины его возникновения включают:
- кислородное голодание;
- травмы;
- переохлаждение;
- сложные условия беременности.
У детей младшего возраста и подростков заболевание может развиваться по следующим причинам:
- множественные травмы;
- осложнения, возникающие вследствие воспалительных процессов, что приводит к нарушению работы почек и печени.
Кроме того, данный синдром может быть вызван тяжелым состоянием после перенесенной инфекционной болезни.

В период беременности
К числу ключевых факторов, способствующих развитию ДВС-синдрома во время беременности, относятся:
- разрыв матки;
- значительная кровопотеря (во время родов или вследствие травм);
- длительное нахождение мертвого плода в матке;
- повреждения родовых путей;
- продолжительная стимуляция родовой активности;
- тяжелое течение беременности.
Для выявления проблем со свертываемостью крови требуется пройти соответствующее обследование.
Симптомы
ДВС-синдром обычно проявляется разнообразными клиническими симптомами. Прежде всего, это связано с появлением кровотечений (из носа, десен, желудочно-кишечного тракта) и образованием гематом.
Кроме того, следует отметить, что данная патология затрагивает практически все системы организма.
К основным симптомам относятся:
- тахикардия;
- рвота с примесями крови;
- маточные кровотечения;
- азотемия;
- цианоз кожи;
- нарушения сознания;
- дыхательная недостаточность;
- пониженное артериальное давление.
Для хронической формы заболевания характерны:
- тромбозы;
- тромбоэмболия.
Этот патологический процесс чаще всего диагностируется у пациентов с злокачественными новообразованиями. Сначала развивается тромбоз глубоких вен, а затем возникает тромбоэмболия легочной артерии. Это одна из наиболее частых причин летального исхода у онкологических больных.
Диагностика
Диагностические мероприятия начинаются с опроса пациента, который позволяет собрать максимум информации о причинах, способствовавших возникновению заболевания, а также о наличии характерных симптомов. Осмотр больного также играет ключевую роль в процессе диагностики: врач обращает внимание на желтизну кожи и слизистых оболочек, а также определяет частоту пульса и уровень артериального давления.
Для определения стадии заболевания проводится лабораторное исследование крови, включая коагулограмму.
Биохимический анализ крови поможет выявить изменения в уровнях холестерина, электролитов, креатинина, глюкозы, мочевой кислоты и антитромбина.
Кроме того, выполняются специальные пробы, которые помогают обнаружить подкожные кровоизлияния.
К аппаратным методам диагностики относятся:
- магнитно-резонансная томография;
- ультразвуковое исследование;
- спиральная компьютерная томография.
Если заболевание развивается у взрослого, может потребоваться консультация терапевта. В случае диагностики заболевания у ребенка необходимо обратиться к гематологу. Женщинам в период беременности поможет акушер-гинеколог.
На основе полученных данных врач устанавливает окончательный диагноз и разрабатывает наиболее эффективный план лечения.
Методы терапии
Пациенты с установленным диагнозом ДВС-синдром нуждаются в медицинской помощи. Основные цели терапии заключаются в следующем:
- устранение первопричины (применяются антибиотики, антивирусные и противогрибковые средства, а также препараты для нормализации артериального давления);
- восстановление кровообращения (вводятся плазмозаменители);
- нормализация свертываемости крови (проводится внутривенное введение тромбоцитов и плазмы, а также переливания).
В некоторых случаях такие меры могут привести к положительным результатам. Если этого не происходит, лечение осуществляется поэтапно.
Ключевые клинические рекомендации:
- Первая стадия. Назначается гепарин, вводятся кортикостероиды и дезагреганты внутривенно в сочетании с реополиглюкином.
- Вторая стадия. К ранее назначенным препаратам добавляются свежезамороженная плазма, эритроцитарная масса и альбумины.
- Третья стадия. Все действия направлены на подавление активности системы, мешающей нормальной свертываемости крови. Назначаются Гордокс, Этамзилат и Контрикал. Гепарин отменяется.
- Четвертая стадия. В этой фазе применяются все процедуры, предусмотренные для третьей стадии, а также добавляется желатиновый раствор и Альбумин.
Если у беременной женщины наблюдается преждевременная отслойка плаценты, возникает необходимость в экстренном стимулировании родов.
Возможные осложнения
ДВС-синдром представляет собой острое патологическое состояние, которое требует немедленного медицинского вмешательства. Игнорирование лечения как у детей, так и у взрослых может привести к серьезным осложнениям.
К числу этих осложнений относятся:
- нарушения функционирования поврежденных органов из-за образования тромбов;
- гемокоагуляционный шок, вызванный резким падением артериального давления;
- пониженный уровень гемоглобина;
- обильные кровотечения;
- анемия.
Если терапевтические мероприятия не будут начаты вовремя, практически каждый случай может закончиться летальным исходом.
Профилактические мероприятия
В качестве профилактических мер при ДВС-синдроме эксперты советуют следовать следующим рекомендациям:
- своевременно устранять факторы, способствующие возникновению заболевания у детей и взрослых;
- при лечении инфекционных заболеваний использовать антикоагулянты;
- избегать контакта с ядохимикатами.
Прогноз заболевания будет зависеть от провоцирующих факторов, проявлений, методов лечения и назначений врача. Чтобы избежать серьезных последствий, при первых симптомах болезни необходимо незамедлительно обратиться за медицинской помощью.
Врач назначит коагулограмму, которая поможет выявить синдром на ранних стадиях, и подберет оптимальный метод лечения.
ДВС-синдром является серьезной патологией с высокой вероятностью летального исхода. Без надлежащего лечения риск смерти составляет почти 100 процентов.
Вопрос-ответ
Как проявляется ДВС-синдром?
ДВС-синдром (синдром диссеминированного внутрисосудистого свертывания) – сложный патологический процесс в системе свертывания крови, характеризующийся нарушением тромбообразования и сопровождающийся как тромбозами, так и кровотечением.
Можно ли вылечить ДВС-синдром?
Лечение ДВС-синдрома направлено на восстановление нормальной работы свертывающей системы крови. Устранение острой патологии требует переливания крови и ее компонентов, а также максимально быстрого устранения причины патологии. Лечение хронических форм также основано на устранении первопричины патологии.
Сколько длится ДВС-синдром?
Стадии ДВС-синдрома. В своем развитии ДВС-синдром проходит следующие стадии (фазы): первичная гиперкоагуляция – в кровь выбрасываются вещества типа тромбопластина, запускающие процессы свертывания. Длительность этой фазы при остром процессе составляет несколько минут или часов, при хроническом может занять месяцы.
Какие тромбы образуются при ДВС синдроме?
ДВС-синдром (диссеминированное внутрисосудистое свёртывание, коагулопатия потребления, тромбогеморрагический синдром) — это патологический неспецифический процесс, характеризующийся образованием диссеминированных тромбов (фибринных, эритроцитарных и гиалиновых) в сосудах микроциркуляторного русла в сочетании с.
Советы
СОВЕТ №1
Изучите основные симптомы ДВС-синдрома, такие как кровотечения, тромбообразование и нарушения функции органов. Это поможет вам вовремя распознать проблему и обратиться за медицинской помощью.
СОВЕТ №2
Обратите внимание на факторы риска, включая наличие хронических заболеваний, беременность или операции. Знание этих факторов поможет вам и вашему врачу разработать план профилактики.
СОВЕТ №3
Регулярно проходите медицинские обследования, особенно если вы находитесь в группе риска. Раннее выявление и лечение могут значительно улучшить прогноз при ДВС-синдроме.
СОВЕТ №4
Следите за своим образом жизни: сбалансированное питание, физическая активность и отказ от вредных привычек могут снизить риск развития ДВС-синдрома и улучшить общее состояние здоровья.